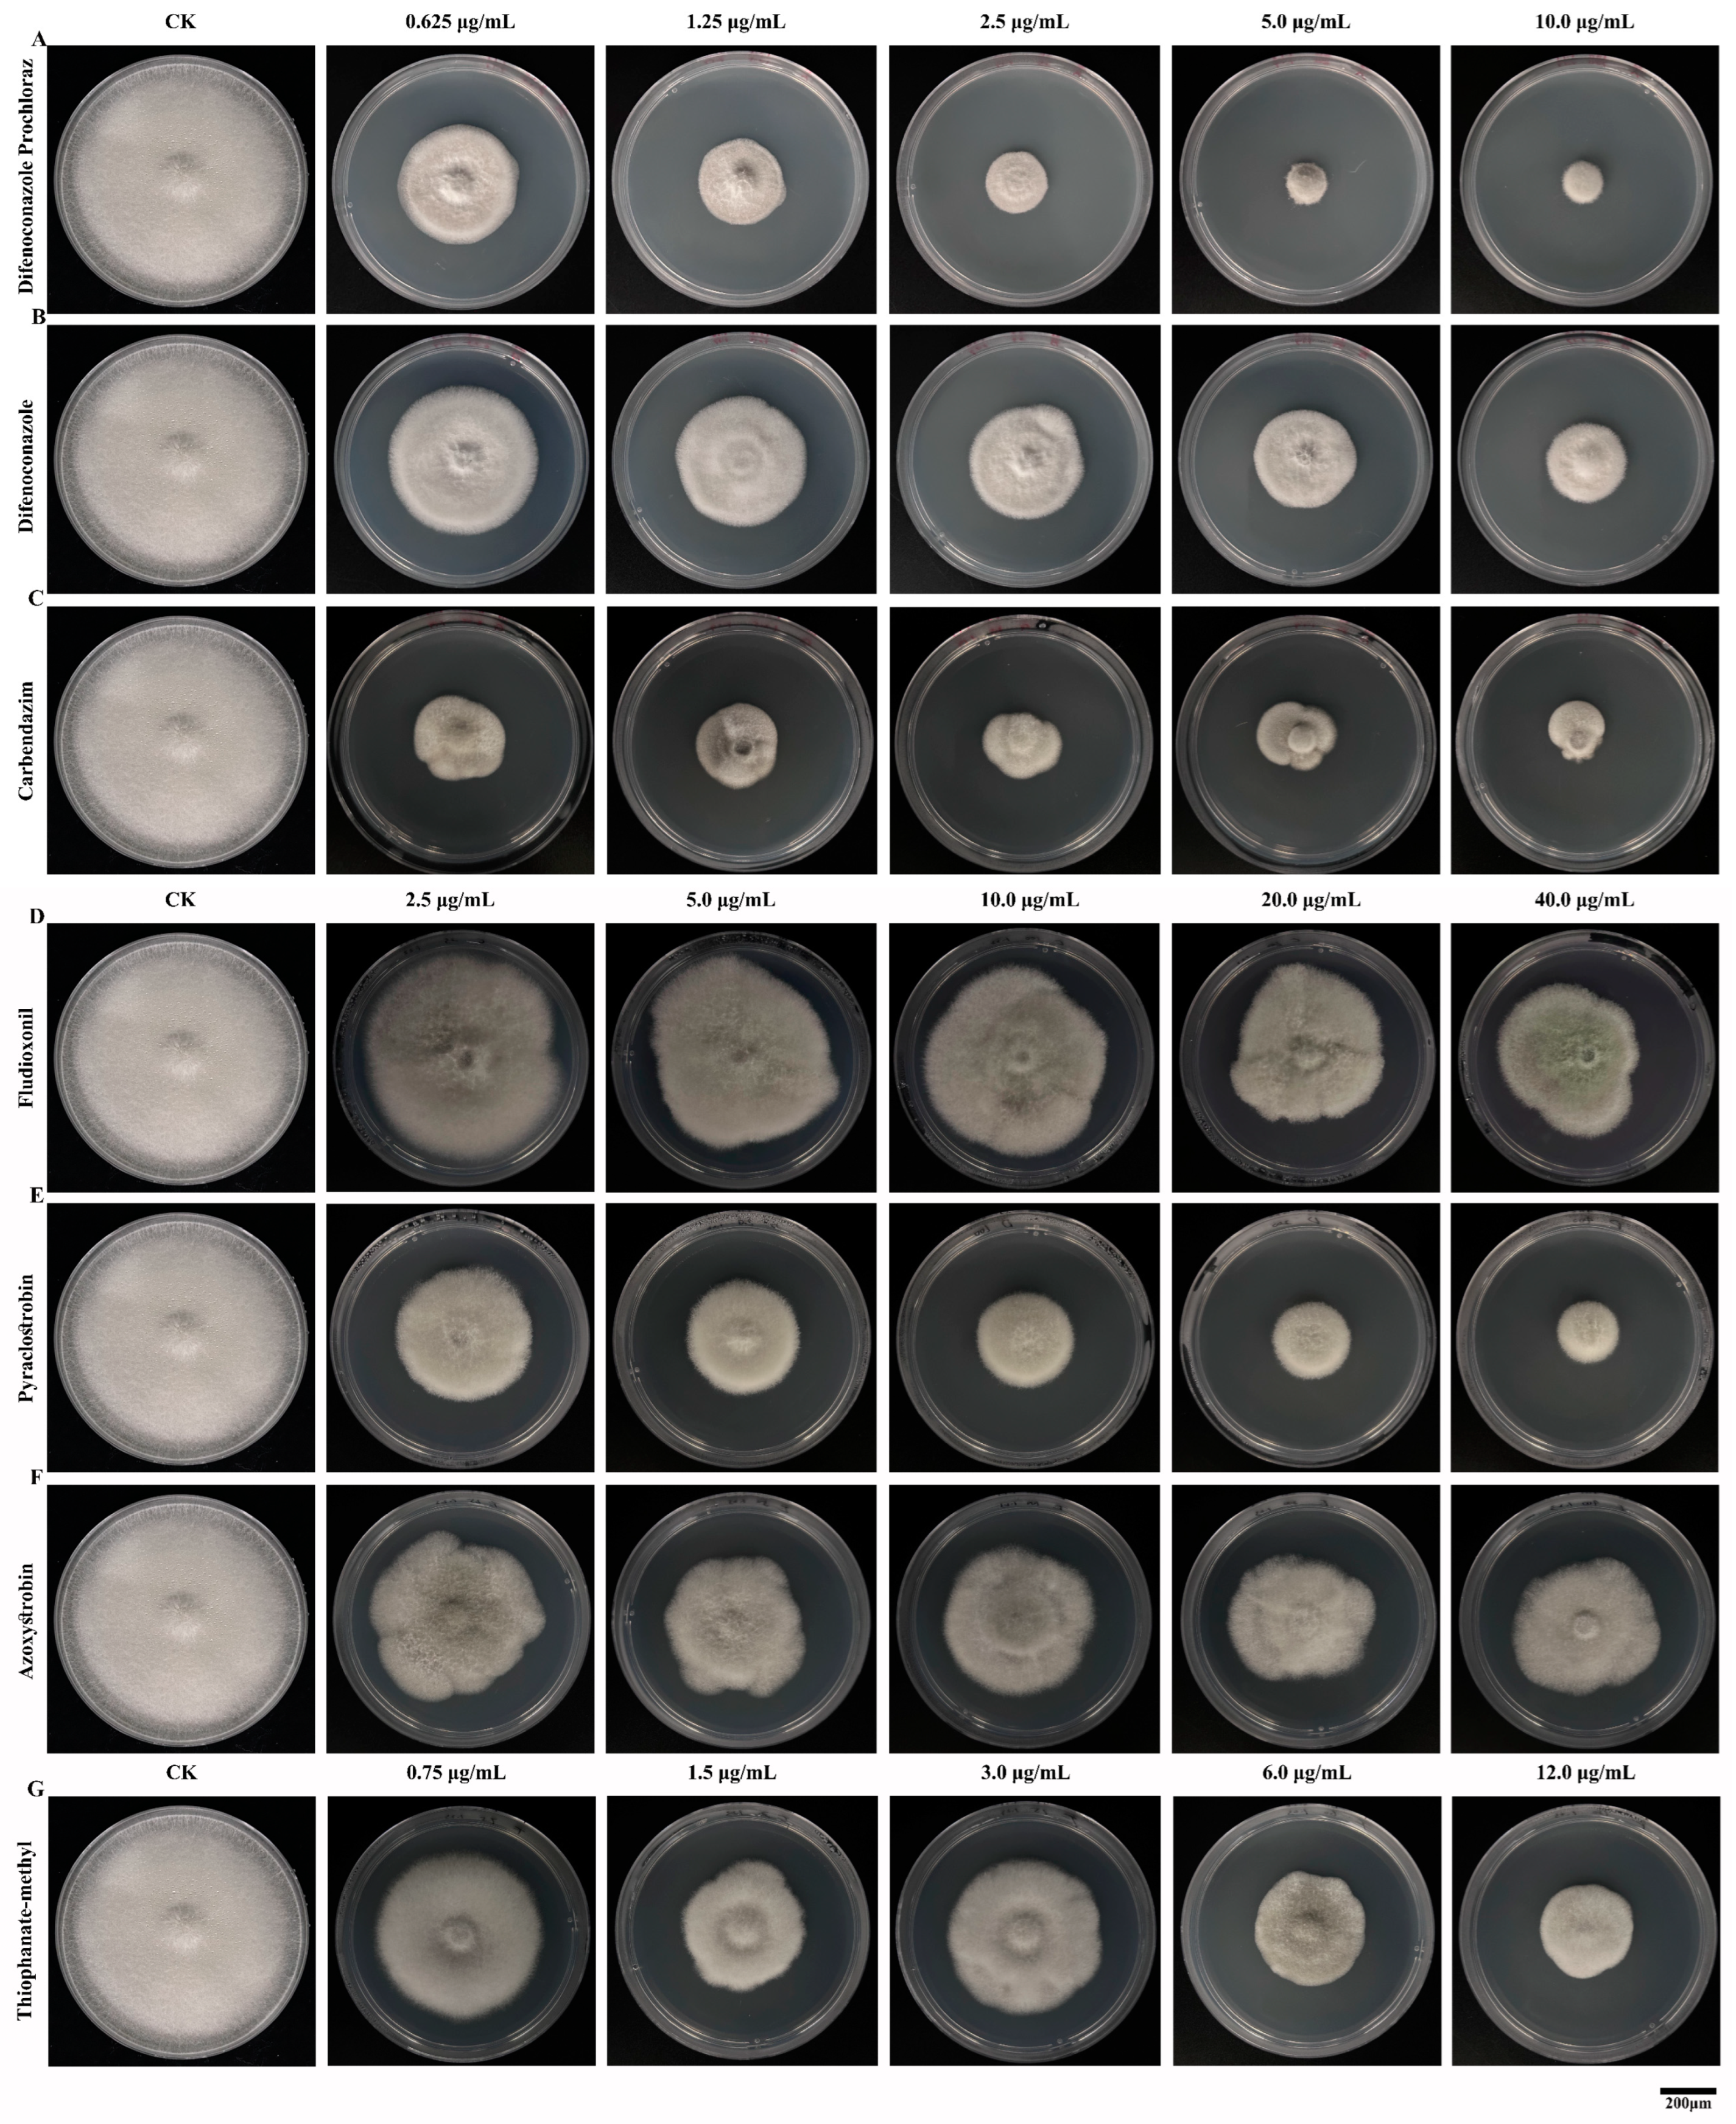

Biological Characteristics and Fungicide Screening of Colletotrichum fructicola Causing Mulberry Anthracnose
Abstract
1. Introduction
2. Materials and Methods
2.1. Pathogenic Fungus Strains, Growth Conditions and Fungicides
2.2. Effects of Different Media on the Growth of C. fructicola
2.3. Effects of Different Temperatures on the Growth of C. fructicola
2.4. Effect of pH on Colony Growth and Sporulation of Mulberry Anthracnose
2.5. Effect of Photoperiod on Colony Growth and Sporulation of Mulberry Anthracnose
2.6. Determination of Mycelial Lethal Temperature of C. fructicola
2.7. Screening of Indoor Fungicides for C. fructicola
2.8. The Effect of Fungicides on the Mycelial Morphology of C. fructicola
2.9. Statistical Analysis
3. Results
3.1. The Effect of Culture Medium on the Growth and Sporulation of C. fructicola
3.2. Effects of Different Temperatures on Colony Growth and Sporulation of C. fructicola
3.3. The Effect of Different pH on Colony Growth and Sporulation of C. fructicola
3.4. The Effect of Light Periods on Colony Growth and Sporulation of C. fructicola
3.5. Determination of the Lethal Temperature for Mycelia of Mulberry Anthracnose
3.6. Comparison of Indoor Virulence of Several Fungicides Against Mulberry Anthracnose
3.7. Effects of Fungicides on the Mycelial Morphology of Mulberry Anthracnose
4. Discussion
5. Conclusions
Author Contributions
Funding
Data Availability Statement
Conflicts of Interest
References
- Gnanesh, B.N.; Mondal, R.; Arunakumar, G.S.; Manojkumar, H.B.; Singh, P.; Bhavya, M.R.; Sowbhagya, P.; Burji, S.M.; Mogili, T.; Sivaprasad, V. Genome size, genetic diversity, and phenotypic variability imply the effect of genetic variation instead of ploidy on trait plasticity in the cross-pollinated tree species of mulberry. PLoS ONE 2023, 18, e0289766. [Google Scholar] [CrossRef] [PubMed]
- Jiao, F.; Luo, R.S.; Dai, X.L.; Liu, H.; Yu, G.; Han, S.H.; Lu, X.; Su, C.; Chen, Q.; Song, Q.X.; et al. Chromosome-Level Reference Genome and Population Genomic Analysis Provide Insights into the Evolution and Improvement of Domesticated Mulberry (Morus alba). Mol. Plant 2020, 13, 1001–1012. [Google Scholar] [CrossRef] [PubMed]
- Li, P.; Wang, S.Y.; Liu, M.Y.; Dai, X.; Shi, H.C.; Zhou, W.H.; Sheng, S.; Wu, F.A. Antibacterial Activity and Mechanism of Three Root Exudates from Mulberry Seedlings against Ralstonia pseudosolanacearum. Plants 2024, 13, 482. [Google Scholar] [CrossRef] [PubMed]
- Saira, A.; Muhammad, I.W.; Ghulam, R.; Atta, U.; Muhammad, N.S.; Akhtar, H.; Khizar, R. Inhibitory Effects of Different Fungicides against Anthracnose of Chillie (Colletotrichum capsici). Plant Health 2023, 2, 173–179. [Google Scholar]
- Dean, R.; Van Kan, J.A.; Pretorius, Z.A.; Hammond-Kosack, K.E.; Di Pietro, A.; Spanu, P.D.; Rudd, J.J.; Dickman, M.; Kahmann, R.; Ellis, J.; et al. The Top 10 fungal pathogens in molecular plant pathology. Mol. Plant Pathol. 2012, 13, 414–430. [Google Scholar] [CrossRef]
- Hara, K. Pathology of Practical Crops; Youkendo: Tokyo, Japan, 1925; pp. 148–149. [Google Scholar]
- Hara, K. The Catalog of Fungi in Japan; The Mycological Society of Japan: Gifu, Japan, 1954; p. 400. [Google Scholar]
- Yoshida, S.; Shirata, A.; Yoshida, S.; Kobayashi, T. Anthracnose fungi, Colletotrichum dematium, C. acutatum, Glomerellac ingulata isolated from diseased mulberry leaves and their pathogenicity. Ann. Phytopathol. Soc. Jpn. 1995, 61, 75–81. [Google Scholar] [CrossRef][Green Version]
- Yoshida, S.; Shirata, A. Annual development of mulberry anthracnose caused by Colletotrichum dematium in relation to position of leaves in tree. J. Sericultural Sci. Jpn. 1998, 67, 327–332. [Google Scholar]
- Yoshida, S.; Shirata, A.; Hiradate, S. Ecological characteristics and biological control of mulberry anthracnose. Jpn. Agric. Res. Q. 2002, 36, 89–95. [Google Scholar] [CrossRef][Green Version]
- Yoshida, S. Studies on ecology and control of mulberry anthracnose. Jpn. J. Phytopathol. 2003, 69, 179–180. [Google Scholar] [CrossRef][Green Version]
- Yoshida, S.; Shirata, A. Survival of Colletotrichum dematium in soil and infected mulberry leaves. Plant Dis. 1999, 83, 465–468. [Google Scholar] [CrossRef]
- Tian, L.D. Research on the occurrence and prevention of mulberry anthracnose disease. Seric. Sci. 1982, 8, 76–81. [Google Scholar]
- Jayawardena, R.S. Colletotrichum: Lifestyles, biology, morpho-species, species complexes and accepted species. Mycosphere 2021, 12, 519–669. [Google Scholar] [CrossRef]
- Yan, J.; Wu, P.S.; Du, H.Z.; Zhang, Q.E. First Report of Black Spot Caused by Colletotrichum gloeosporioides on Paper Mulberry in China. Plant Dis. 2011, 95, 880. [Google Scholar] [CrossRef]
- Xue, L.; Zhang, L.; Yang, X.X.; Huang, X.; Wu, W.; Zhou, X.; White, J.F.; Liu, Y.; Li, C. Characterization, Phylogenetic Analyses, and Pathogenicity of Colletotrichum Species on Morus alba in Sichuan Province, China. Plant Dis. 2019, 103, 2624–2633. [Google Scholar] [CrossRef]
- Zhu, Z.X.; Dong, Z.X.; Mo, R.L.; Zhang, C.; Zuo, Y.Y.; Yu, C.; Hu, X.M. First Report of Colletotrichum aenigma Causing Anthracnose on Mulberry Leaves in China. Plant Dis. 2023, 107, 571. [Google Scholar] [CrossRef]
- Dos Santos, G.C.; Lima Horn, L.M.; Trezzi Casa, R.; Gorayeb, E.S.; Nascimento da Silva, F.; Bogo, A.; Nascimento, S.C.D.; Soardi, K.; Sartori Pereira, F.; Gonçalves, M.J. First Report of Colletotrichum fructicola Causing Anthracnosis on Glycine max in Brazil. Plant Dis. 2023, 108, 814. [Google Scholar] [CrossRef] [PubMed]
- Chu, L.L.; Lou, J.W.; Liu, W.B.; Jin, P.F.; Miao, W.G. Identification of rubber anthracnose fungus HD-1 and screening of antagonistic agents. J. Biol. 2023, 40, 32–38. [Google Scholar]
- Weir, B.; Johnston, P.; Damm, U. The Colletotrichum gloeosporioides species complex. Stud. Mycol. 2012, 73, 115–180. [Google Scholar] [CrossRef]
- Sun, W.; Chen, S.N.; Yan, X.J.; Yuan, H.Z. Application of fungicides to control anthrax in China. Mod. Pestic. 2022, 21, 1–6. [Google Scholar]
- Elshahawy, I.E.; Darwesh, O.M. Preventive and curative effect of difenoconazole + azoxytrobin and thiophanate-methyl against lucky bamboo anthracnose disease caused by Colletotrichum dracaenophilum. Heliyon 2023, 9, e14444. [Google Scholar] [CrossRef]
- Liu, B.; Stein, L.; Cochran, K.; du Toit, L.J.; Feng, C.; Correll, J.C. Three New Fungal Leaf Spot Diseases of Spinach in the United States and the Evaluation of Fungicide Efficacy for Disease Management. Plant Dis. 2021, 105, 316–323. [Google Scholar] [CrossRef] [PubMed]
- Forcelini, B.B.; Rebello, C.S.; Wang, N.Y.; Peres, N.A. Fitness, competitive ability, and mutation stability of isolates of Colletotrichum acutatum from strawberry resistant to QoI fungicides. Phytopathology 2018, 108, 462–468. [Google Scholar] [CrossRef] [PubMed]
- Chung, W.H.; Ishii, H.; Nishimura, K.; Fukaya, M.; Yano, K.; Kajitani, Y. Fungicide Sensitivity and Phylogenetic Relationship of Anthracnose Fungi Isolated from Various Fruit Crops in Japan. Plant Dis. 2006, 90, 506–512. [Google Scholar] [CrossRef] [PubMed]
- MacKenzie, S.J.; Mertely, J.C.; Peres, N.A. Curative and Protectant Activity of Fungicides for Control of Crown Rot of Strawberry Caused by Colletotrichum gloeosporioides. Plant Dis. 2009, 93, 815–820. [Google Scholar] [CrossRef] [PubMed]
- Meng, K.; Zhang, Y.B.; Chang, J.; Li, Z.H.; Wang, D.; Zhai, F.Y.; Shu, J.P. Toxicity determination of 8 fungicides against 9 pathogens of anthracnose disease in thin shelled walnuts. For. Sci. Res. 2021, 34, 153–164. [Google Scholar]
- Sharma, A.; Sharma, I.M.; Sharma, M. Efficacy and economics of fungicides for management of mango anthracnose. Indian Phytopathol. 2019, 72, 361–366. [Google Scholar] [CrossRef]
- Dong, G.R.; Zhang, Y.; Liang, X.; Wang, M.; Ye, Q.Q.; Xian, X.W.; Yang, Y. Resistance characterization of the natural population and resistance mechanism to pyraclostrobin in Lasiodiplodia theobromae. Pestic. Biochem. Physiol. 2022, 188, 105232. [Google Scholar] [CrossRef]
- Piccirillo, G.; Carrieri, R.; Polizzi, G.; Azzaro, A.; Lahoz, E.; Fernández-Ortuño, D.; Vitale, A. In vitro and in vivo activity of QoI fungicides against Colletotrichum gloeosporioides causing fruit anthracnose in Citrus sinensis. Sci. Hortic. 2018, 236, 90–95. [Google Scholar] [CrossRef]
- Eckert, M.R.; Rossall, S.; Selley, A.; Fitt, B.D. Effects of fungicides on in vitro spore germination and mycelial growth of the phytopathogens Leptosphaeria maculans and L. biglobosa (phoma stem canker of oilseed rape). Pest. Manag. Sci. 2010, 66, 396–405. [Google Scholar] [CrossRef]
- Peres, N.A.R.; Souza, N.L.; Zitko, S.E.; Timmer, L.W. Activity of Benomyl for Control of Postbloom Fruit Drop of Citrus Caused by Colletotrichum acutatum. Plant Dis. 2002, 86, 620–624. [Google Scholar] [CrossRef]
- Gama, A.B.; Baggio, J.S.; Rebello, C.S.; Lourenço, S.A.; Gasparoto, M.C.G.; da Silva Junior, G.J.; Peres, N.A.; Amorim, L. Sensitivity of Colletotrichum acutatum Isolates from Citrus to Carbendazim, Difenoconazole, Tebuconazole, and Trifloxystrobin. Plant Dis. 2020, 104, 1621–1628. [Google Scholar] [CrossRef]
- Bordoloi, G.N.; Kumari, B.; Guha, A.; Bordoloi, M.; Yadav, R.; Roy, M.K.; Bora, T.C. Isolation and structure elucidation of a new antifungal and antibacterial antibiotic produced by Streptomyces sp. Biosci. Biotechnol. Biochem. 2001, 65, 1856–1858. [Google Scholar] [CrossRef] [PubMed]
- Tang, X.L.; Yang, J.G.; Zhuoma, G.; Guo, X.Y.; Cao, P.X.; Yi, B.L.; Wang, W.M.; Ji, D.; Pasquali, M.; Baccelli, I.; et al. Biological characterization and in vitro fungicide screenings of a new causal agent of wheat Fusarium head blight in Tibet, China. Front. Microbiol. 2022, 13, 941734. [Google Scholar] [CrossRef] [PubMed]
- Mtimet, N.; Guégan, S.; Durand, L.; Mathot, A.G.; Venaille, L.; Leguérinel, I.; Coroller, L.; Couvert, O. Effect of pH on Thermoanaerobacterium thermosaccharolyticum DSM 571 growth, spore heat resistance and recovery. Food Microbiol. 2016, 55, 64–72. [Google Scholar] [CrossRef]
- Momotaz, R.; Alam, K.M.; Arifunnahar, M.; Islam, M.N.; Alam, M.M.; Hossain, M.M.; Siddique, S.S. Colletotrichum siamense leaf blight/spot: Characterization of a newly identified disease on Cinnamomum tamala. J. Basic Microbiol. 2023, 63, 915–929. [Google Scholar] [CrossRef]
- Rosenzweig, N.; Hanson, L.E.; Mambetova, S.; Jiang, Q.W.; Guza, C.; Stewart, J.; Somohano, P. Fungicide Sensitivity Monitoring of Alternaria spp. Causing Leaf Spot of Sugarbeet (Beta vulgaris) in the Upper Great Lakes. Plant Dis. 2019, 103, 2263–2270. [Google Scholar] [CrossRef]
- Mo, F.; Hu, X.; Ding, Y.; Li, R.; Li, M. Naturally produced magnolol can significantly damage the plasma membrane of Rhizoctonia solani. Pestic. Biochem. Physiol. 2021, 178, 104942. [Google Scholar] [CrossRef] [PubMed]
- de Menezes, H.D.; Massola, N.S., Jr.; Flint, S.D.; Silva, G.J.; Bachmann, L., Jr.; Rangel, D.E.; Braga, G.U. Growth under visible light increases conidia and mucilage production and tolerance to UV-B radiation in the plant pathogenic fungus Colletotrichum acutatum. Photochem. Photobiol. 2015, 91, 397–402. [Google Scholar] [CrossRef]
- Cannon, P.F.; Damm, U.; Johnston, P.R.; Weir, B.S. Colletotrichum–Current status and future directions. Stud. Mycol. 2012, 73, 181–213. [Google Scholar] [CrossRef]
- Trkulja, V.; Čojić, B.; Trkulja, N.; Tomić, A.; Matić, S.; Ikanović, J.; Popović Milovanović, T. Colletotrichum Species Associated with Apple Bitter Rot and Glomerella Leaf Spot: A Comprehensive Overview. J. Fungi 2024, 10, 660. [Google Scholar] [CrossRef]
- Marin-Felix, Y.; Groenewald, J.Z.; Cai, L.; Chen, Q.; Marincowitz, S.; Barnes, I.; Bensch, K.; Braun, U.; Camporesi, E.; Damm, U.; et al. Genera of phytopathogenic fungi: GOPHY1. Stud. Mycol. 2017, 86, 99–216. [Google Scholar] [CrossRef] [PubMed]
- Pardo-De la Hoz, C.J.; Calderon, C.; Rincon, A.M.; Cardenas, M.; Danies, G.; Lopez-Kleine, L.; Restrepo, S.; Jimenez, P. Species from the Colletotrichum acutatum, Colletotrichum boninense and Colletotrichum gloeosporioides species complexes associated with tree tomato and mango crops in Colombia. Plant Pathol. 2016, 65, 227–237. [Google Scholar] [CrossRef]
- Ciofini, A.; Negrini, F.; Baroncelli, R.; Baraldi, E. Management of Post-Harvest Anthracnose: Current Approaches and Future Perspectives. Plants 2022, 11, 1856. [Google Scholar] [CrossRef]
- Talhinhas, P.; Baroncelli, R. Colletotrichum species and complexes: Geographic distribution, host range and conservation status. Fungal Divers. 2021, 110, 109–198. [Google Scholar] [CrossRef]
- Nandeesha, C.V.; Akbari, L.F.; Jaiswal, A.; Harsha, B.R.; Patil, B.; Bhaliya, C.M.; Kumar, N.; Singh, T.; Jain, S. Control efficacy and yield response of different fungicides evaluated against anthracnose of green gram. Crop Prot. 2023, 174, 106432. [Google Scholar] [CrossRef]
- Dorigan, A.F.; Moreira, S.I.; da Silva Costa Guimarães, S.; Cruz-Magalhães, V.; Alves, E. Target and non-target site mechanisms of fungicide resistance and their implications for the management of crop pathogens. Pest. Manag. Sci. 2023, 79, 4731–4753. [Google Scholar] [CrossRef]
- Yin, Y.N.; Miao, J.Q.; Shao, W.Y.; Liu, X.L.; Zhao, Y.F.; Ma, Z.H. Fungicide Resistance: Progress in Understanding Mechanism, Monitoring, and Management. Phytopathology 2023, 113, 707–718. [Google Scholar] [CrossRef]
- Wong, F.P.; Midland, S.L. Sensitivity distributions of California populations of Colletotrichum cereale to the DMI fungicides propiconazole, myclobutanil, tebuconazole, and triadimefon. Plant Dis. 2007, 91, 1547–1555. [Google Scholar] [CrossRef]
- Fan, R.; Liu, Y.; Bin, Y.; Huang, J.; Yi, B.; Tang, X.; Li, Y.; Cai, Y.; Yang, Z.; Yang, M.; et al. Identification of Colletotrichum aenigma as the new causal agent of leaf blight disease on Aucuba japonica Thunb, and screenings of effective fungicides for its sustainable management. Front. Microbiol. 2023, 14, 1222844. [Google Scholar] [CrossRef]
- Moreira, R.R.; Hamada, N.A.; Peres, N.A.; De Mio, L.L.M. Sensitivity of the Colletotrichum acutatum Species Complex from Apple Trees in Brazil to Dithiocarbamates, Methyl Benzimidazole Carbamates, and Quinone Outside Inhibitor Fungicides. Plant Dis. 2019, 103, 2569–2576. [Google Scholar] [CrossRef]
- Li, F.X.; Chen, J.W.; Chen, Q.; Liu, Z.Y.; Sun, J.Y.; Yan, Y.T.; Zhang, H.X.; Bi, Y. Identification, pathogenicity, and sensitivity to fungicide of Colletotrichum species that causes walnut anthracnose in Beijing. Agronomy 2023, 13, 214. [Google Scholar] [CrossRef]
- Hsieh, T.F.; Shen, Y.M.; Huang, J.H.; Tsai, J.N.; Lu, M.T.; Lin, C.P. Insights into Grape Ripe Rot: A Focus on the Colletotrichum gloeosporioides Species Complex and Its Management Strategies. Plants 2023, 12, 2873. [Google Scholar] [CrossRef] [PubMed]
- Karim, M.M.; Usman, H.M.; Tan, Q.; Hu, J.J.; Fan, F.; Hussain, R.; Luo, C.X. Fungicide resistance in Colletotrichum fructicola and Colletotrichum siamense causing peach anthracnose in China. Pestic. Biochem. Physiol. 2024, 203, 106006. [Google Scholar] [CrossRef] [PubMed]
- da Silva, L.L.; Moreno, H.L.A.; Correia, H.L.N.; Santana, M.F.; de Queiroz, M.V. Colletotrichum: Species complexes, lifestyle, and peculiarities of some sources of genetic variability. Appl. Microbiol. Biotechnol. 2020, 104, 1891–1904. [Google Scholar] [CrossRef]

| Fungicide | Manufacturer | Concentration (μg/mL) |
|---|---|---|
| 35% Difenoconazole Prochloraz AEC | Qingdao Hansheng Biological Technology Co., Ltd. (Qingdao, China) | 0.625, 1.250, 2.500, 5.000, 10.000 |
| 25% Difenoconazole EC | Shenzhen Noposion Agrochemical Co., Ltd. (Shenzhen, China) | 0.625, 1.250, 2.500, 5.000, 10.000 |
| 97% Carbendazim WP | Shanghai Aladdin Biochemical Technology Co., Ltd. (Shanghai, China) | 0.625, 1.250, 2.500, 5.000, 10.000 |
| 500 g·L−1 Thiophanate-Methyl SC | Jiangsu Longdeng Chemical Co., Ltd. (Lianyungang, China) | 0.750, 1.500, 3.000, 6.000, 12.000 |
| 25 g·L−1 Fludioxonil SSCC | Xianzhengda Nantong Crop Protection Co., Ltd. (Nantong, China) | 2.500, 5.000, 10.000, 20.000, 40.000 |
| 25% Pyraclostrobin SC | Jinan Luba Pesticide Co., Ltd. (Jinan, China) | 2.500, 5.000, 10.000, 20.000, 40.000 |
| 250 g·L−1 Azoxystrobin SC | Syngenta, (Basel, Switzerland) | 2.500, 5.000, 10.000, 20.000, 40.000 |
| Fungicide Name | Concentration (μg/mL) | Inhibitory Rates (%) |
|---|---|---|
| 35% Difenoconazole Prochloraz AEC | 10.000 | 87.19 |
| 5.000 | 86.88 | |
| 2.500 | 79.63 | |
| 1.250 | 66.20 | |
| 0.625 | 53.70 | |
| CK | - | |
| 25% Difenoconazole EC | 10.000 | 65.12 |
| 5.000 | 54.63 | |
| 2.500 | 48.46 | |
| 1.250 | 47.38 | |
| 0.625 | 39.04 | |
| CK | - | |
| 97% Carbendazim WP | 10.000 | 79.32 |
| 5.000 | 71.91 | |
| 2.500 | 75.62 | |
| 1.250 | 66.98 | |
| 0.625 | 67.13 | |
| CK | - | |
| 500 g·L−1 Thiophanate-Methyl SC | 12.000 | 63.12 |
| 6.000 | 52.47 | |
| 3.000 | 46.30 | |
| 1.500 | 31.17 | |
| 0.750 | 27.16 | |
| CK | - | |
| 25 g·L−1 Fludioxonil SSCC | 40.000 | 37.35 |
| 20.000 | 29.94 | |
| 10.000 | 22.80 | |
| 5.000 | 16.05 | |
| 2.500 | 11.11 | |
| CK | - | |
| 25% Pyraclostrobin SC | 40.000 | 74.38 |
| 20.000 | 66.05 | |
| 10.000 | 60.19 | |
| 5.000 | 45.06 | |
| 2.500 | 49.51 | |
| CK | - | |
| 250 g·L−1 Azoxystrobin SC | 40.000 | 44.44 |
| 20.000 | 42.90 | |
| 10.000 | 38.27 | |
| 5.000 | 38.58 | |
| 2.500 | 26.39 | |
| CK | - |
| Fungicide Names | Regression Equation | R2 | EC50/(μg·L−1) |
|---|---|---|---|
| 35% Difenoconazole Prochloraz AEC | y = 0.9261× + 5.3506 | 0.9370 | 0.4180 |
| 25% Difenoconazole EC | y = 0.5035× + 4.8241 | 0.9386 | 2.2350 |
| 97% Carbendazim WP | y = 0.2954× + 5.4774 | 0.7405 | 0.0242 |
| 500 g·L−1 Thiophanate-Methyl SC | y = 0.8101× + 4.4545 | 0.9767 | 4.7138 |
| 25 g·L−1 Fludioxonil SSCC | y = 0.7515× + 3.4873 | 0.9988 | 103.0170 |
| 25% Pyraclostrobin SC | y = 0.7908× + 4.3966 | 0.9808 | 5.7946 |
| 250 g·L−1 Azoxystrobin SC | y = 0.3637× + 4.3286 | 0.7991 | 70.1499 |
Disclaimer/Publisher’s Note: The statements, opinions and data contained in all publications are solely those of the individual author(s) and contributor(s) and not of MDPI and/or the editor(s). MDPI and/or the editor(s) disclaim responsibility for any injury to people or property resulting from any ideas, methods, instructions or products referred to in the content. |
© 2024 by the authors. Licensee MDPI, Basel, Switzerland. This article is an open access article distributed under the terms and conditions of the Creative Commons Attribution (CC BY) license (https://creativecommons.org/licenses/by/4.0/).
Share and Cite
Li, P.; Dai, X.; Wang, S.; Luo, Q.; Tang, Q.; Xu, Z.; Zhao, W.; Wu, F. Biological Characteristics and Fungicide Screening of Colletotrichum fructicola Causing Mulberry Anthracnose. Microorganisms 2024, 12, 2386. https://doi.org/10.3390/microorganisms12122386
Li P, Dai X, Wang S, Luo Q, Tang Q, Xu Z, Zhao W, Wu F. Biological Characteristics and Fungicide Screening of Colletotrichum fructicola Causing Mulberry Anthracnose. Microorganisms. 2024; 12(12):2386. https://doi.org/10.3390/microorganisms12122386
Chicago/Turabian StyleLi, Ping, Xue Dai, Siyi Wang, Qian Luo, Qingqing Tang, Zijing Xu, Weiguo Zhao, and Fuan Wu. 2024. "Biological Characteristics and Fungicide Screening of Colletotrichum fructicola Causing Mulberry Anthracnose" Microorganisms 12, no. 12: 2386. https://doi.org/10.3390/microorganisms12122386
APA StyleLi, P., Dai, X., Wang, S., Luo, Q., Tang, Q., Xu, Z., Zhao, W., & Wu, F. (2024). Biological Characteristics and Fungicide Screening of Colletotrichum fructicola Causing Mulberry Anthracnose. Microorganisms, 12(12), 2386. https://doi.org/10.3390/microorganisms12122386

